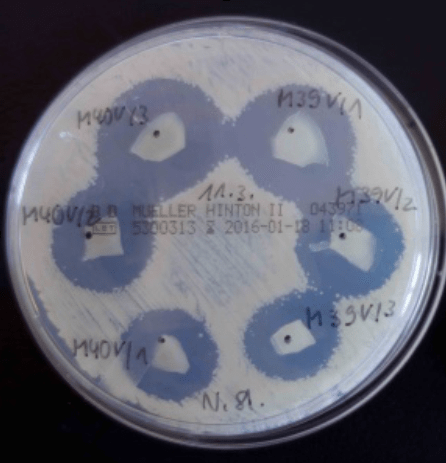

High Tech Forschung in der Kosmetikherstellung
Wir sind immer auf der Suche nach den neuesten Wirkstoffen und Technologien. Auch aus diesem Grund haben wir am Clusterprojekt NANOMAR teilgenommen. In diesem Projekt haben wir uns zum Ziel gesetzt eine Kollagenwundauflage mit Mikro- und Nanopartikeln aus marinen Organismen herzustellen. Dieser soll sowohl die Wundheilung fördern, aber auch gegen Antiobiotika-resistente Keime wirken.
Dieses Projekt konnte nun zusammen mit unseren Partnern erfolgreich abgeschlossen werden.
Kosmetikforschung in Deutschland
Unser Clusterprojekt mit dem Institut für Marine Biotechnologie (An-Institut der Universität Greifswald) , dem Forschungsinstitut für Leder- und Kunststoffbahnen (An-Insitut der Bergakademie Freiberg), Blue Biotech GmbH und der Medical Biomaterial Products GmbH ist nun erfolgreich abgeschlossen.
![]()
![]()


Der Titel des Clusterprojektes lautet: „NANOMAR – Mikro- und Nanopartikel aus marinen Organismen (Maresome®) in Kollagen-Wundauflagen zur Verhinderung der Kolonisation multiresistenter Erreger“.
Wir haben uns innerhalb dieses Verbundes zum Ziel gesetzt, eine stabile, weiterverwendbare Formulierung aus den Wirkstoffen der Algen und einem geeigneten Kollagen für die Produktion im Labor- und Technikumsmaßstab zu erarbeiten.
Dieses Fortschungsprojekt wurde vom Bundesforschungsministerium mit einer Laufzeit von 3 Jahren gefördert. Das Bundesministerium für Bildung und Forschung will mit seiner Fördermaßnahme „KMU-innovativ“ kleine und mittelständische Unternehmen bei der Spitzenforschung in wichtigen Zukunftsbereichen unterstützen. Wir haben uns mit unserem Verbundprojekt auf die Bekanntmachung „KMU-innovativ: Nanotechnologie“ bezogen.
Der Einsatz von marinen Wirkstoffen bietet in Zeiten von Überbevölkerung und der dadurch eintretenden Ressourcenknappheit einen interessanten Lösungsansatz zumindest von daraus resultierenden Teilproblemen.
Auch die gesellschaftliche Debatte erlaubt es nur noch schwerlich, wenn Flächen an Land für den Anbau von nicht-essbaren Rohstoffen genutzt werden und somit den traditionellen Anbau von Nahrungsmitteln verhindern, wenn andererseits Millionen Menschen auf der Welt an Hunger leiden. Daher ist der Ansatz, die Möglichkeiten der deutlich größeren Fläche des Meeres für den Anbau von Ressourcen zu nutzen, höchst interessant.
Durch den extensiven Gebrauch von pharmazeutischen Mitteln, wie zum Beispiel Antibiotika, entstehen unweigerlich Resistenzen. Diesen kann einerseits durch den immer höheren Einsatz jener oder aber durch das Auffinden neuer Materialien bzw. Wirkstoffen begegnet werden.
Unser Wundverband sollte insbesondere gegen MRSA Verkeimungen nachweisbare Wirkungen aufweisen.
Eine Wundheilung auf Basis der hochmodernen, lipidhaltigen, antibakteriell wirkenden Nanopartikel (Maresome®) mit Verbindung zu einer wundheilungsfördernden Kollagenauflage stellt daher einen komplett neuen Wundheilungsansatz dar.
Wir sind daher sehr erfreut – gemeinsam mit unseren Partnern dieses Projekt erfolgreich abgeschlossen zu haben.
Als abschließender Wirknachweis kann ein Hemmhoftest dienen.
Hierbei wird eine Petrischale mit MRSA Keimen geimpft und auf dieser werden einige von uns hergestellte Kollagenvliese mit Maresomen verteilt. So kann genau betrachtet werden, dass der Verband die Kolonisation von MRSA Keimen verhindert. Um die Vliese herum sind keine MRSA Keime mehr vorhanden.